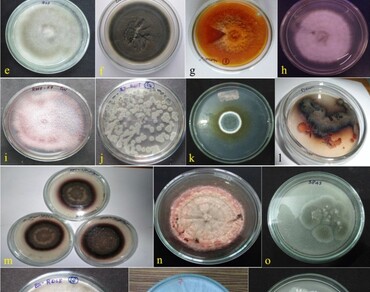
Distribution, molecular characterization and phosphate solubilization activity of culturable endophytic fungi from crop plant roots in North East (NE) India

Vol 37 Issue 6, December 2024
Total Articles: 47

Assessment of antibacterial activities of mycelium and exopolysaccharide extract of two different Lentinus species collected from Tripura
Research Articles
Views: 3410
Pages: 2372-2379
Published: 02 October, 2023
Doi: 10.1007/s42535-023-00726-x

Wedge and side grafting: a boon for mass multiplication of jackfruit (Artocarpus hetrophylus L.) plants under subtropical humid condition
Research Articles
Views: 3406
Pages: 2380-2391
Published: 02 October, 2023
Doi: 10.1007/s42535-023-00735-w

In vitro responses of Lotus corniculatus L. cultivar “Leo” to PEG‑induced drought stress
Research Articles
Views: 4035
Pages: 2392-2399
Published: 03 October, 2023
Doi: 10.1007/s42535-023-00736-9
Distribution, molecular characterization and phosphate solubilization activity of culturable endophytic fungi from crop plant roots in North East (NE) India
Research Articles
Views: 3669
Pages: 2400-2412
Published: 07 October, 2023
Doi: 10.1007/s42535-023-00743-w

Genetic diversity and genetic analysis for pigmented pericarps in rice (Oryza sativa L.)
Research Articles
Views: 4088
Pages: 2413-2422
Published: 09 October, 2023
Doi: 10.1007/s42535-023-00721-2

Effect of modified MS medium on in vitro propagation of Indigofera barberi Gamble An endemic hepatoprotective, recalcitrant medicinal plant of Seshachalam Biosphere reserve
Research Articles
Views: 4108
Pages: 2423-2429
Published: 12 October, 2023
Doi: 10.1007/s42535-023-00741-y

GC–MS analysis and antioxidant evaluation of two Aurèsian Asteraceae species Artemisia herba-alba Asso. and Artemisia campestris L.
Research Articles
Views: 4442
Pages: 2430-2438
Published: 18 October, 2023
Doi: 10.1007/s42535-023-00750-x

Efficient decolourization of toluidine blue and methylene blue using Bacillus cereus
Research Articles
Views: 3671
Pages: 2439-2447
Published: 18 October, 2023
Doi: 10.1007/s42535-023-00747-6

TDZ and zeatin induced in vitro shooting for efficient vegetative propagation in Trillium govanianum, an endangered alpine medicinal herb
Research Articles
Views: 3463
Pages: 2448-2456
Published: 23 October, 2023
Doi: 10.1007/s42535-023-00746-7